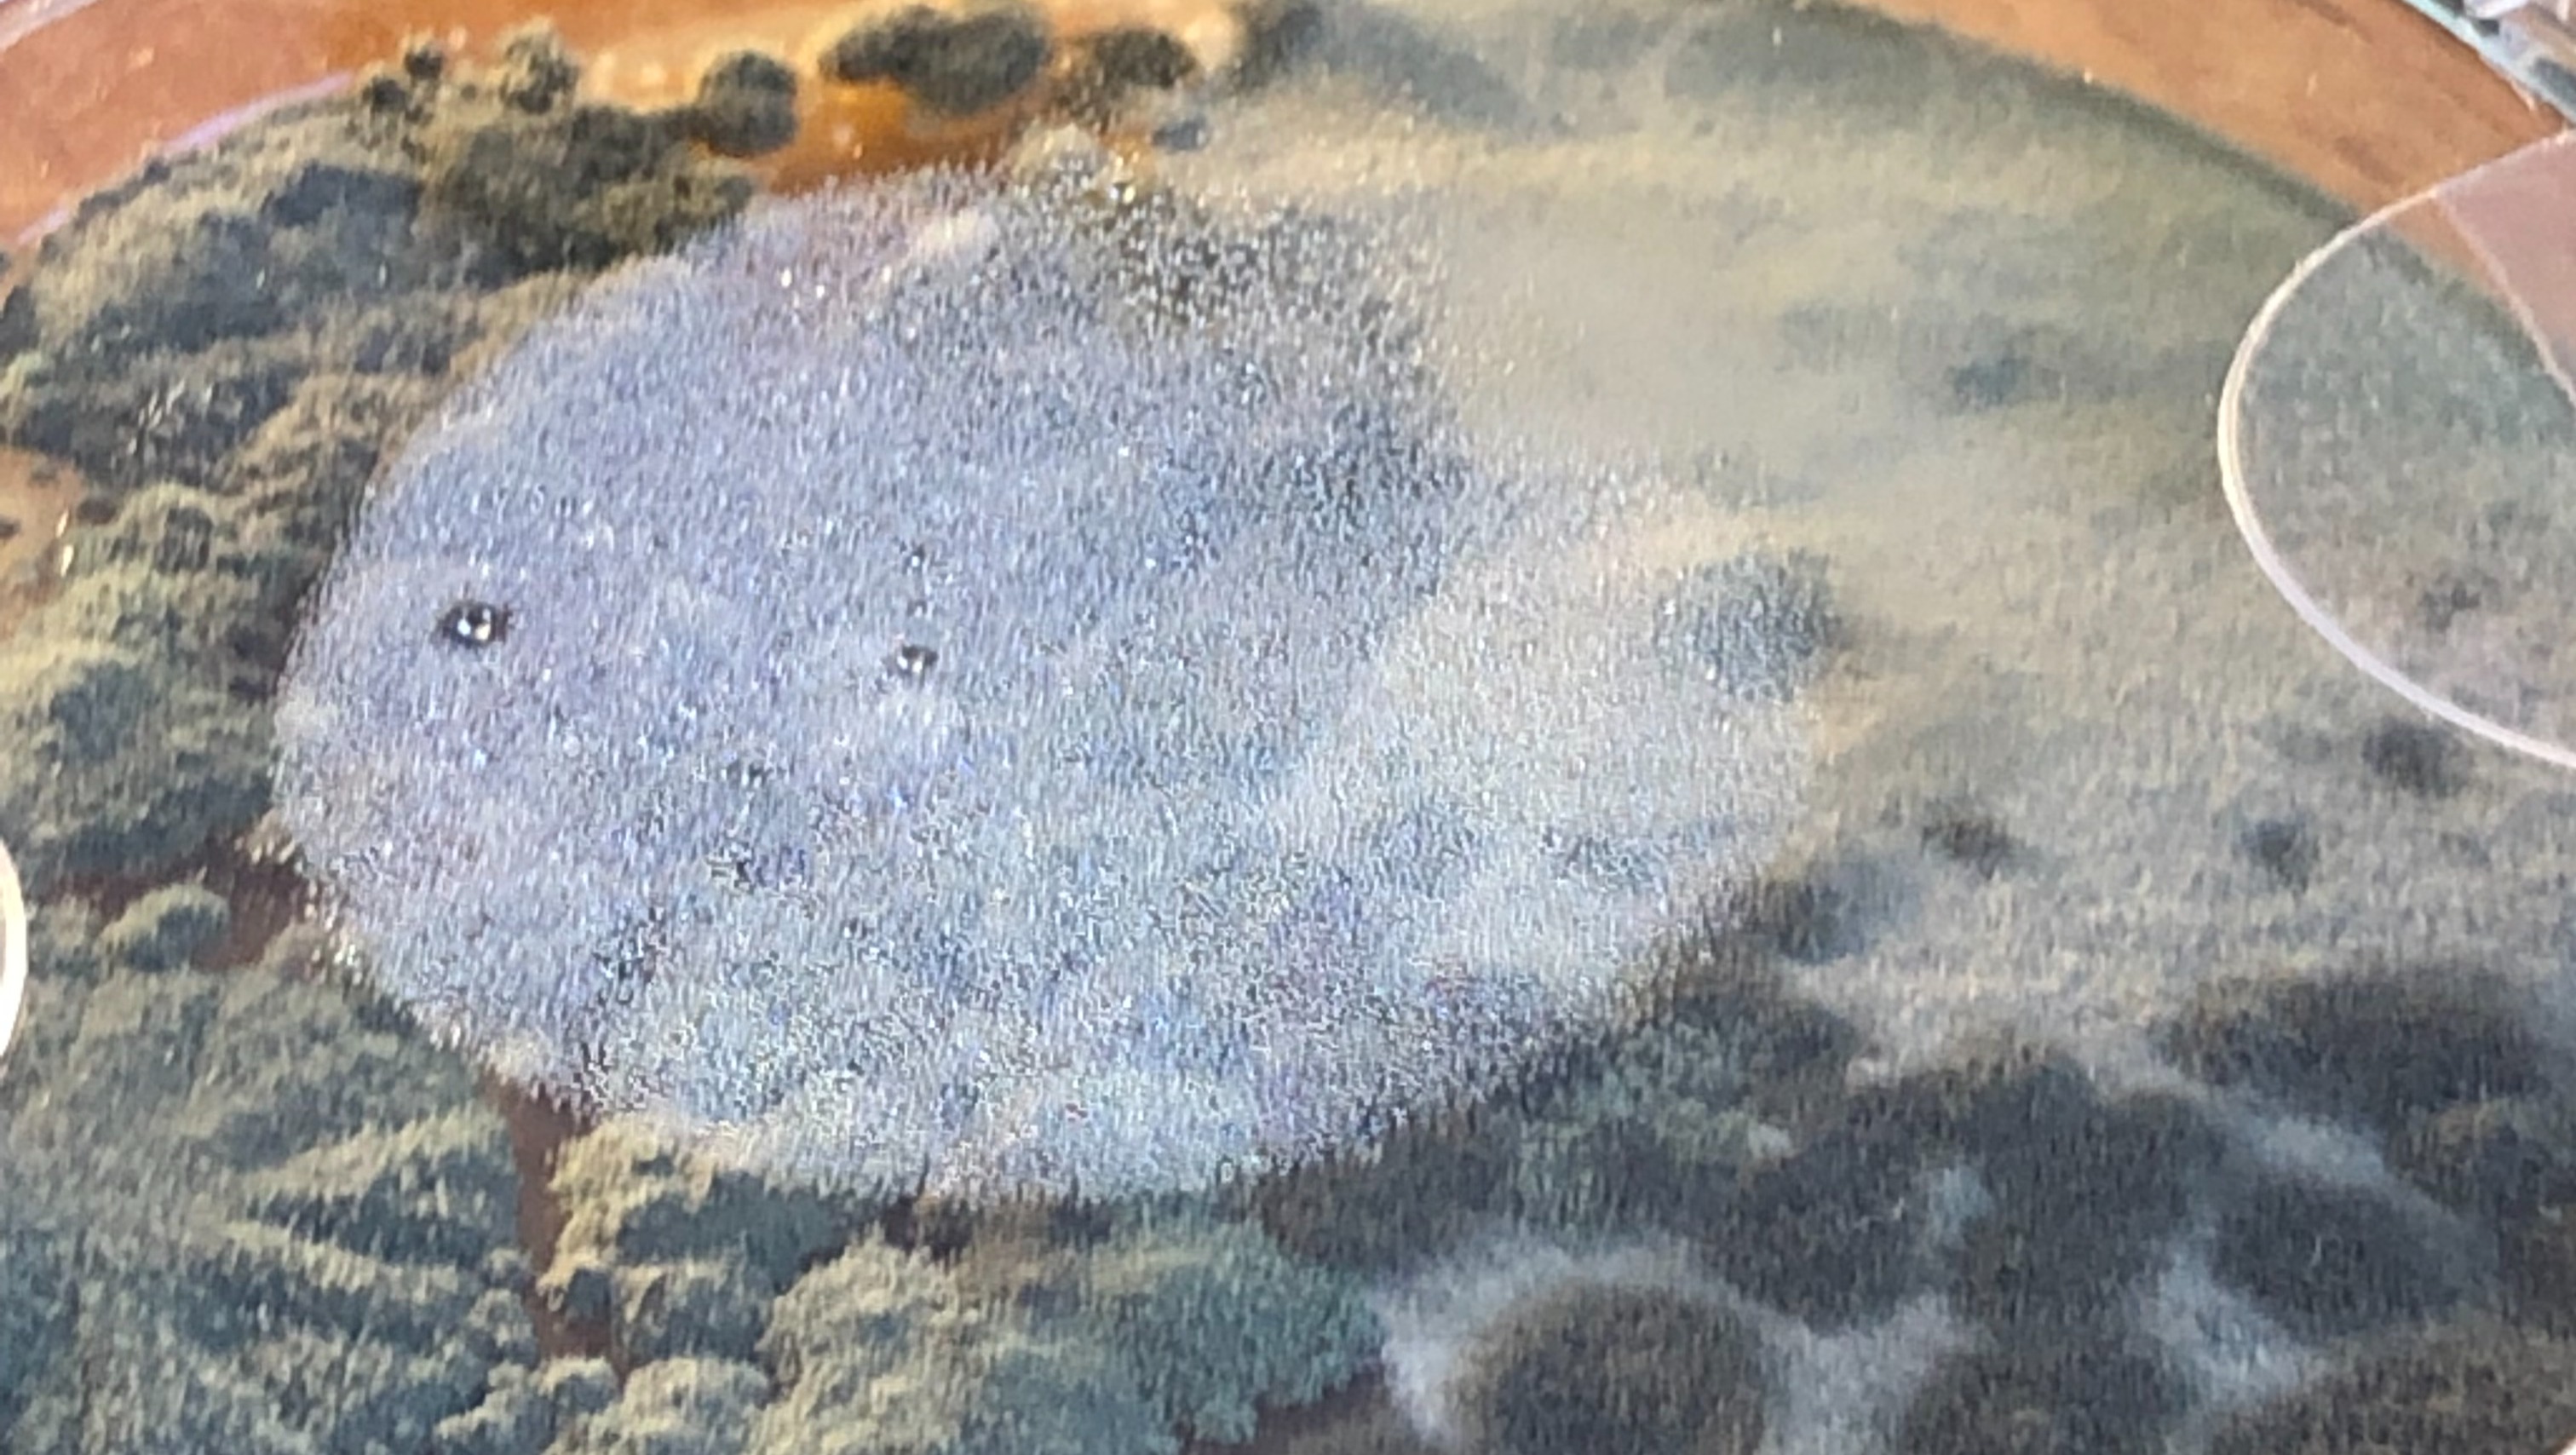

Ik ben Ruud van der Meer CIRS schimmel patiënt sinds mijn 8 e jaar en ik wil het bedrijf www.giftigeschimmels.nl gaan opzetten in Nederland om schimmel patiënten te gaan genezen. Hiervoor zijn artsen medicatie en schoonmaakmiddelen nodig die veel geld kosten wat ik dus zelf niet heb. En deze groep van ziektes word niet verzekerd in Nederland.
Organizer
Ruud van der Meer
Organizer





